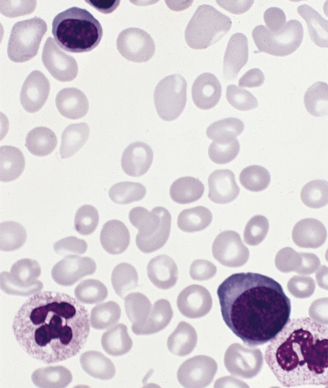

Ruxolitinib was significantly better than the best available therapy in a phase III, open-label trial of patients with polycythemia vera who were resistant to or intolerant of hydroxyurea.
Polycythemia vera, myeloid metaplasia phase
Ruxolitinib was significantly better than the best available therapy in a phase III, open-label trial of patients with polycythemia vera (PV) who were resistant to or intolerant of hydroxyurea. Results from the RESPONSE trial were presented at the 2014 American Society of Clinical Oncology (ASCO) Annual Meeting in Chicago.
PV is a myeloproliferative neoplasm characterized by debilitating symptoms and poor quality of life; there is also potential for life-threatening cardiovascular complications related to both thrombosis and hemorrhage, according to Srdan Verstovsek, MD, of the MD Anderson Cancer Center in Houston. Generally, therapy is aimed at controlling hematocrit (Hct) below 45%, which can decrease the risk of cardiovascular death and thrombotic events.
In this trial, ruxolitinib was compared with best-available therapy (BAT) in 222 patients. All patients had active disease, meaning requirement for regular phlebotomy and splenomegaly.
The primary endpoint was a composite of Hct control (≤ 45%) and a reduction in spleen volume of at least 35%. At 32 weeks, with about 90% of each group still on its assigned therapy, the composite endpoint was met in 21% of ruxolitinib patients and in only 1% of BAT patients, for an odds ratio of 28.64 (95% CI, 4.50-1206; P < .0001). Taken individually, 38% of ruxolitinib achieved the spleen volume reduction endpoint compared with only 1% of BAT patients; 60% and 20% of the two groups achieved Hct control. Also, between weeks 8 and 32, the phlebotomy rate was three times higher in the BAT group than in the ruxolitinib group.
Notably, the responses with ruxolitinib were very durable. Only one patient lost a primary response 37.1 weeks after the response began, and the probability of maintaining a response at 1 year was 94%. At a median follow-up of 81 weeks, 93 of the 110 (85%) ruxolitinib patients remained on the treatment.
“Quality of life is a very important aspect of PV patients, because they have a long life to live with PV,” Verstovsek said. A 50% improvement in a general symptoms score was achieved in 49% of ruxolitinib patients and 5% of BAT patients; various individual symptoms also were significantly reduced in ruxolitinib patients while either staying the same or worsening with BAT. There was only one thromboembolic event on ruxolitinib, compared with six on BAT.
“These data demonstrate in our minds that ruxolitinib may be a valuable new therapeutic option in this patient population,” Verstovsek said.
Guido Marcucci, MD, of Ohio State University Comprehensive Cancer Center, was the discussant for the session and agreed that this is a promising new therapy. He noted that virtually all patients in the BAT group were allowed to cross over to ruxolitinib after the 32 week analysis, and we do not yet have data on how they fare with the drug as a secondary therapy.
“Given the impact that it had on patients, will clinicians start to consider this also as a primary therapy?” he wondered. “I don’t think they should, because it is not an approved drug.” Furthermore, integrating genetic and epigenetic information into trials could help further select patients who will benefit from the therapy.
Navigating AE Management for Cellular Therapy Across Hematologic Cancers
A panel of clinical pharmacists discussed strategies for mitigating toxicities across different multiple myeloma, lymphoma, and leukemia populations.